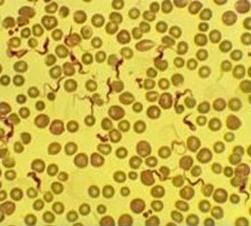
錐體蟲屬

分類地位:錐體蟲屬(Trypanosoma)是原生動物門、鞭毛蟲綱、動基體目、錐體蟲科的一屬。
錐體蟲屬
錐體蟲屬形態特徵:蟲體狹長,葉形,一端尖,另一端鈍圓或尖,前端具1根鞭毛。胞核單個,在體中部。動核在體後端。從位於體後端的毛基體長出一鞭毛,沿身體一邊向前伸,與體表面構成一波動膜。鞭毛末端游離。
生活習性:寄生於脊椎動物的血液中,以滲透方式取得營養。
命名發現:此屬的蟲種最早由Valentin於1841年在鱒魚的血液中發現,但至1843年Gruby 才命名為Trypanosoma。
生活史:繁殖為縱二分法。生活史包括2個宿主,一個為脊椎動物,一個為無脊椎動物。以吸血的無脊椎動物為中間宿主(節肢動物或水蛭類)。在中間宿主的消化系統內,經一系列變化,再被傳給脊椎動物。許多種類能使宿主致病,但對魚的危害目前尚不太清楚。據文獻所載,本屬生活史中,可形成利什曼原蟲型、細滴蟲型、短膜蟲型和錐體蟲各期的蟲體。
分布範圍 錐體蟲在我國的分布較廣泛。
主要種類:錐體蟲在我國的分布較廣泛,發現的種類有:秉志錐體蟲(T. pingi Chen & Hsieh)、黃顙錐體蟲(T. pseudobagri Dogiel & Achmerov )、青魚錐體蟲(T. mylopharyngodoni Chen)、北京錐體蟲(T. peikinensis Chen & Hsieh)、鯇錐體蟲(T. ctenopharyngodoni Chen & Hsieh)、鰱錐體蟲(T. hypophthalmichthysi Chen & Hsieh)、鱅錐體蟲(T. aristichthysi Chen)、鮰錐體蟲(T. liocassis Dogiel & Achmerov);泥鰍錐體蟲(T. misgurni Zho & Ma)、印江錐體蟲(T. yinjiangensis Li & Feng )、鱯錐體蟲(T. hemibagri Zhang & Ma)等。

